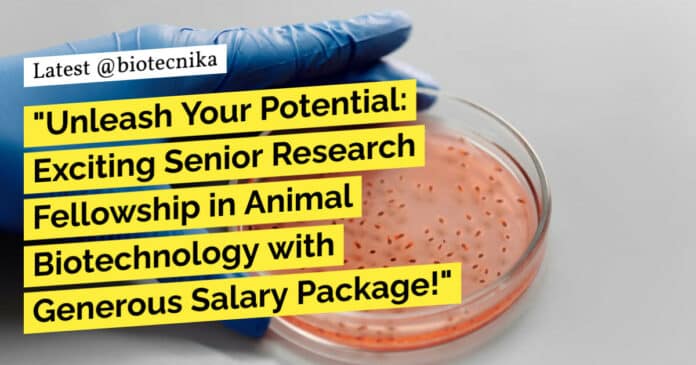

NIAB Mol Bio SRF Job Opening – Applications Invited
We are pleased to announce an exciting opportunity for a Senior Research Fellowship at the National Institute of Animal Biotechnology (NIAB), a premier autonomous institute under the Department of Biotechnology, Ministry of Science & Technology, Government of India. NIAB is dedicated to cutting-edge research and development in the field of animal biotechnology.
Position: Senior Research Fellowship (1 Position)
Project Title: Molecular biological studies on porcine reproductive & respiratory syndrome (PRRS) virus in pig population of North East Region of India for development of sustainable diagnostics and vaccine
Principal Investigator: Dr. Madhuri Subbiah
Requirements:
Master’s degree in a relevant subject with 4 years / 5 years of Bachelor’s degree. Candidates with post-graduate degrees in basic sciences with 3 years Bachelor’s degree and 2 years Master’s degree should have ICAR/UGC/CSIR NET qualifications and 2 years of research experience. Previous work experience in molecular cloning, Lateral Flow Assay development, cell and virus culture, and basic molecular biology techniques (preferred)
Desired Experience:
Conducting molecular cloning and basic molecular biology techniques, Developing Lateral Flow Assays. Working with cell and virus culture. Contributing to the overall research project on PRRS virus in pig population
Age: 35 years (Relaxation is admissible in case
of SC/ST/OBC candidates as per Government instructions)Salary and Benefits:
The selected candidate will receive a fellowship amount of Rs. 31,000/- + HRA (if applicable) as per ICAR guidelines.
How to Apply:
To apply, please email your photograph, resume, and copies of documents supporting your date of birth, educational qualifications, and experience certificates to [email protected]. The deadline for applications is 12th October 2023.
Interview Details:
The online walk-in interview will be conducted on 16th October 2023 from 10.00 AM onwards. Eligible shortlisted candidates will receive the online interview link via email.
Click here for the notification
Keywords: National Institute of Animal Biotechnology, Senior Research Fellowship, PRRS virus, molecular cloning, Lateral Flow Assay development, cell culture, virus culture, molecular biology techniques, scientific research. NIAB Mol Bio SRF Job Opening – Applications Invited. Please ensure you are subscribed to the Biotecnika Times Newsletter and our YouTube channel to be notified of the latest industry news. Follow us on social media like Twitter, Telegram, Facebook